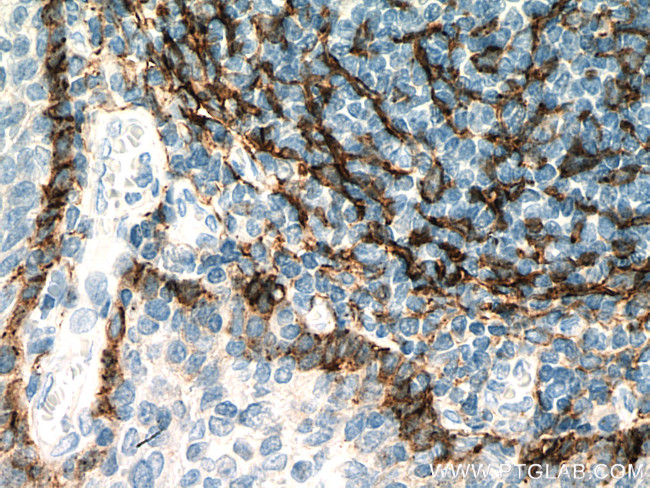
Podoplanin Antibody in Immunohistochemistry (Paraffin) (IHC (P))

Search
Proteintech
Podoplanin Monoclonal Antibody (1D9F3)
{{$productOrderCtrl.translations['antibody.pdp.commerceCard.promotion.promotions']}}
{{$productOrderCtrl.translations['antibody.pdp.commerceCard.promotion.viewpromo']}}
{{$productOrderCtrl.translations['antibody.pdp.commerceCard.promotion.promocode']}}: {{promo.promoCode}} {{promo.promoTitle}} {{promo.promoDescription}}. {{$productOrderCtrl.translations['antibody.pdp.commerceCard.promotion.learnmore']}}
产品信息
67432-1-IG
种属反应
宿主/亚型
分类
类型
克隆号
抗原
偶联物
形式
浓度
规格
纯化类型
保存液
内含物
保存条件
运输条件
产品详细信息
Aliquoting is unnecessary for -20°C storage.
靶标信息
Podoplanin (PDPN, T1A, gp38, Aggrus) is a mucin type-1 glycoprotein with a 40-43 kDa molecular weight. Podoplanin is expressed in many tumors and normal cells, especially lymphatic epithelial cells and follicular DCs. Podoplanin localizes in stromal cells of peripheral lymphoid tissue and thymic epithelial cells. As a regulator of the lymphatic endothelium, podoplanin probably plays a role in maintaining the unique shape of podocytes. Podoplanin appears to serve as a ligand for CLEC-2 and expression is positively correlated with tumors expressing greater invasive and metastatic potential. Podoplanin is directly involved in cell migration, aids metastases formation and tumor cell invasion of tissue. Further, it has also been determined that podoplanin expression is induced through Src activation of Cas and, recently, there are indications of podoplanin presence on Th17 cells. Initial studies below indicate the presence of podoplanin on a small but distinct population of CD4+ cells from human PBMC. Dysfunction of the podoplanin protein has been linked to diseases such as lymphangioma and subglottis neoplasm. Podoplanin has also been proposed as a marker for lung injury due to the physiological function of the protein.
仅用于科研。不用于诊断过程。未经明确授权不得转售。
生物信息学
蛋白别名: Aggrus; CTA-520D8.1; Glycoprotein 36; glycoprotein, 36-KD; Gp36; hT1alpha-1; hT1alpha-2; lung type I cell membrane associated glycoprotein; lung type-I cell membrane-associated glycoprotein (T1A-2); lung type-I cell membrane-associated protein; membrane associated mucin-type glycoprotein; OTTHUMP00000009640; OTTHUMP00000044504; PA2.26 antigen; Podoplanin; RP23-348F1.2; T1-alpha; T1A; transmembrane mucin-type glycoprotein; unnamed protein product
基因别名: AGGRUS; D2-40; GP36; Gp38; GP40; HT1A-1; OTS8; PA2.26; PDPN; PSEC0003; PSEC0025; T1A; T1A-2; T1A2; TI1A
UniProt ID: (Human) Q86YL7
Entrez Gene ID: (Human) 10630